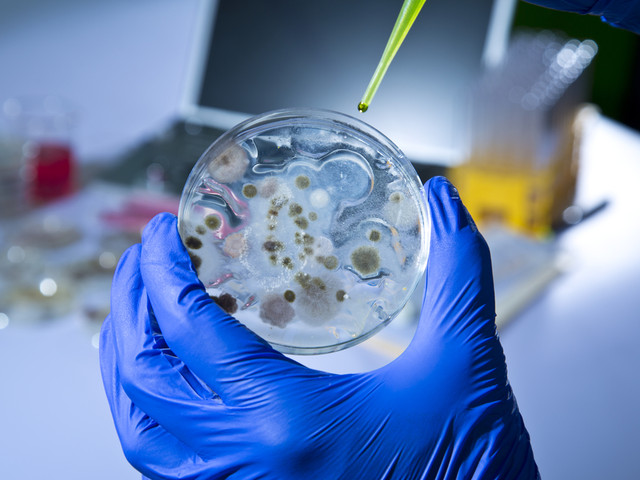

„Мъжкият грип“ не е мит, показва ново изследване на Харвардския университет.
„Мъжкият грип“ не е мит, показва ново изследване на Харвардския университет.
Поради липсата на женски полови хормони имунната система на мъжете отслабва и така те се разболяват по-лесно. Според учените липсата на естроген прави господата по-податливи на пневмония и други респираторни заболявания.
Изследван е ефектът на бактериална пневмония върху мишки, като техните бели дробове са били заразени с болестта. Проф. Лестър Кобзик открил, че женските мишки са естествено по-устойчиви на заболяването. Тази устойчивост се дължи на ензима NOS3, който се активира чрез освобождаването на женския полов хормон естроген. След това при други мъжки и женски заразени мишки е отстранен генът, отговорен за производството на NOS3.
По този начин женските мишки вече не са по-устойчиви на инфекции. Чрез инжектиране на доза естроген както на мъжките, така и на женските мишки възстановяването на белите им дробове било много по-бързо в сравнение с нормалните мишки.
Екипът се надява, че това откритие в бъдеще може да бъде използване за засилване на устойчивостта срещу често срещани и сериозни инфекции в белите дробове и да се възпрепятства прерастването на грима в пневмония, информира БГНЕС.


Дискусия
Няма коментари.